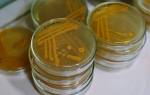

Мазок на заболевания урогенитальной сферы — один из самых распространенных и информативных методов анализа в современной медицине. С его помощью можно выявить не только банальные воспаления, но и предупредить развитие онкологических заболеваний. Несмотря на надежность и доступность метода, не все женщины осознают необходимость регулярного посещения гинеколога и сдачи анализов и нередко обращаются к врачу только в запущенных случаях.
Показания к назначению анализа мазка у женщин
Каждая женщина хоть раз в своей жизни, посещая гинеколога, сдавала мазок на микрофлору или скрытые инфекции. Мазок берется со стенок влагалища, цервикального канала и шейки матки. В лабораторных условиях проводится микроскопическое исследование клеток, содержащихся в биологическом материале. Такой анализ позволяет оценить состояние эпителиальных клеток матки и влагалища, выявить патогенные микроорганизмы и заболевания, передающиеся половым путем. Мазок желательно сдавать регулярно, раз в год, даже если у женщины нет видимых поводов для беспокойства, поскольку многие инфекции в течение длительного времени могут не вызывать никаких симптомов.
В обязательном порядке назначается мазок в тех случаях, когда женщина жалуется на зуд и жжение в области половых органов, необычные выделения из них, внезапную боль внизу живота. Как правило, эти признаки указывают на наличие какого-либо заболевания, диагностировать которое можно только с помощью анализа мазка. Кроме того, желательно провести исследование биоматериала в том случае, если у женщины произошел незащищенный контакт с малоизвестным ей партнером и есть риск заразиться инфекционным заболеванием, передающимся половым путем.
Также врач-гинеколог назначает обязательную сдачу анализа мазка женщинам, планирующим беременность, готовящимся к ЭКО или другим процедурам искусственного оплодотворения (ВРТ). Женщинам, ожидающим ребенка, анализ мазка проводится трижды на всем протяжении срока, поскольку инфекции способны передаваться от матери к ребенку, осложнять роды или вызывать выкидыш.
В гинекологии существует несколько типов анализа мазка в зависимости от вида исследования.
Появление на питательном субстрате колоний микроорганизмов говорит о наличии заболевания. Метод посева также используется для определения стратегии лечения, поскольку во время созревания колонии можно выяснить, к воздействию каких групп антибиотиков она особенно неустойчива.
- Мазок на скрытые инфекции . К скрытым инфекциям относят группу болезней, которые могут бессимптомно протекать на протяжении нескольких месяцев или даже лет, вызывая осложнения, а некоторых случаях — даже бесплодие. На сегодняшний день наиболее достоверным способом выявления скрытых инфекций является исследование мазка при помощи ПЦР (полимеразной цепной реакции). Этот метод используется для диагностики инфекций, не обнаруживаемых в общих мазках. Для проведения анализа берется секрет из шейки матки, влагалища или мочеиспускательного канала и производится многоэтапное повышение концентрации нуклеиновой кислоты и копирование отдельных фрагментов ДНК присутствующих в мазке микроорганизмов. В результате врач может установить видовую и родовую принадлежность всех патогенных бактерий и их способность вызывать развитие заболеваний. В большинстве случаев ПЦР-анализ применятся при подозрении на наличие заболеваний, передающихся половым путем и имеющих на ранних стадиях практически бессимптомное течение. Преимуществами метода являются:
- высокая точность определения возбудителя инфекции;
- возможность определения именно наличия вируса, а не продуктов его жизнедеятельности или распада;
- возможность постановки точного диагноза на основе всего одной клетки микроорганизма.
- Мазок на онкоцитологию, или тест по Папаниколау (пап-тест) , позволяет выявить наличие онкологических заболеваний в шейке матки на ранних стадиях и вовремя начать терапию. Пап-тест определяет большинство воспалительных заболеваний, дисплазию эпителия и злокачественные образования. Сдавать этот мазок рекомендуется ежегодно всем женщинам в возрасте от 21 до 65 лет. В случае если у женщины наблюдаются нарушения менструального цикла, воспалительные процессы цервикального канала, бесплодие, врач назначит мазок на онкоцитологию в обязательном порядке. Также рекомендуется пройти пап-тест при диагностировании диабета, ожирения 2–3 степени, в период планирования беременности, при приеме гормоносодержщих препаратов и наличии в организме вирусов генитального герпеса и папилломы. При анализе мазка можно получить пять типов результата в зависимости от наличия и степени патологии. Первый тип — это отрицательный показатель, говорящий о том, что никаких отклонений от нормы в организме женщины нет, и она полностью здорова. При втором типе присутствует воспалительное заболевание, требующее лечения. Третий тип свидетельствует о наличии в эпителии единичных клеток с аномальным строением ядра. Четвертый тип — подозрение на злокачественное образование или эрозию шейки матки, генитальный герпес, папиллломовирусную инфекцию, паракератоз. Пятый тип — наличие онкологического заболевания, требующего незамедлительного лечения. Следует помнить, что мазок показывает только степень изменения клеток, но не причину, их вызвавшую. Для постановки диагноза необходимы результаты других анализов, включая биопсию, кольпоскопию и гистологическое исследование. Если в мазке будут найдены атипичные клетки, то в заключении будет об этом написано, а также будет указан тип изменений. Если в расшифровке мазка на цитологию нет особых примечаний, это говорит о том, что в ходе исследования никаких патологий обнаружено не было.
При выборе дня для взятия мазка нужно учитывать менструальный цикл. Желательно сдавать анализ перед началом менструации или через несколько дней после ее окончания (оптимальный срок — пятый день), чтобы избежать попадания крови в мазок. Хотя процедура взятия мазка и не слишком сложна, все же необходимо заранее принять некоторые дополнительные меры, чтобы обеспечить чистоту результата. Подготовка к мазку на инфекции у женщин заключается в следующем:
- Не использовать вагинальные свечи, тампоны, мази перед анализом.
- Отказаться от спринцевания.
- При наличии воспалительного заболевания, сопровождающегося обильным выделением секрета необходимо сначала провести лечение и только после полного выздоровления сдавать мазок.
- Воздержаться от половых контактов в течение одного-двух дней до сдачи анализа.
- Не использовать средства интимной гигиены накануне и в день процедуры.
- Воздержаться от опорожнения мочевого пузыря в ближайшее время перед сдачей мазка.
В остальном женщина может вести обычный образ жизни: не требуется ограничений ни по питанию, ни по физической активности.
Взятие у женщины мазка на флору, на скрытые инфекции и на онкоцитологию несколько различается. Во всех случаях перед процедурой женщина проходит общий гинекологический осмотр на кресле с помощью зеркала.
При мазке на флору после визуальной оценки стенок влагалища врач специальным стерильным шпателем осуществляет забор материала из трех участков — влагалища, шейки матки и наружного отверстия мочеиспускательного канала. В некоторых случаях забор производится только с двух первых участков. Взятый шпателем материал равномерно широким мазком распределяется по стерильному предметному стеклу. Нанесение материала каплей, толстым слоем или небольшим мазком считается неправильным, поскольку затрудняет работу врача-лаборанта. При этом материалы из разных участков должны наносится на стекло отдельно друг от друга. С обратной стороны стекла врач делает пометки о месте взятия мазка: U — мочеиспускательный канал, V — влагалище, С — шейка матки. После этого стекло высушивается и направляется в лабораторию на исследование.
При сдаче мазка у женщин на скрытые инфекции и на онкоцитологию забор материала производится специальной щеточкой или с помощью особых стерильных ватных тампонов. Перед взятием материала обязательно удаляют слизь, так как ее наличие может дать ложный результат. Поскольку большинство микроорганизмов являются внутриклеточными паразитами, точное обнаружение их возможно только при исследовании соскоба со стенок половых органов. При анализе на скрытые инфекции материал со щеточки помещают в физраствор, хранящийся в холодильнике. Мазок на онкоцитологию наносят на предметное стекло и высушивают.
Как правило, процедура забора мазка для женщины практически безболезненна. Неудобство может вызывать соприкосновение с гинекологическим зеркалом из-за разницы температур между телом и металлическим инструментом. При взятии материала тампоном или щеточкой с шейки матки может отмечаться незначительное болевое ощущение, которое проходит сразу после окончания манипуляции. Мазок на онкоцитологию иногда способен вызывать незначительные кровянистые выделения в течение двух-трех дней. Если возникают сильные кровотечения, повышение температуры, боли в животе, то необходимо срочно обратиться к гинекологу, поскольку такие симптомы при взятии мазка нормой не являются.
После проведения анализа мазка пациентка получает результаты, которые полностью зависят от типа, назначенного ей исследования.
При расшифровке анализа мазка на флору необходимо знать показатели нормы:
- Плоский эпителий (пл.эп) — у здоровой женщины этот показатель не должен превышать 15 клеток в поле зрения. Большее их количество говорит о воспалительном процессе, а меньшее — о наличии гормональных нарушений.
- Лейкоциты (L) . Нормальное количество во влагалище — не более 10-ти, а в шейке матки не более 30-ти единиц.
- Палочки Дедерлейна , обеспечивающие нормальную микрофлору женских половых органов. В мазке здоровой женщины они должны присутствовать в большом количестве, поскольку их недостаток свидетельствует о нарушенной микрофлоре влагалища.
- Слизь должна присутствовать в мазке в умеренном количестве. Обильные выделения слизи — признак воспаления или инфекции.
- Грибки рода кандида, гонококки, трихомонады в мазке выявляться не должны. Их наличие свидетельствует о заболевании.
Кроме этих показателей в анализе может быть указана одна из четырех степеней чистоты влагалища. Нормальными являются только первая и вторая степень, третья и четвертая являются признаком заболевания половых путей.
Результаты анализа мазка на скрытые инфекции можно получить через 1–2 суток после сдачи. В некоторых случаях они могут быть готовы прямо в день прохождения процедуры. При помощи мазка выявляются следующие инфекции:
- герпес-вирус человека 1 и 2 типов;
- вирус Эпштейна-Барр;
- цитомегаловирус;
- герпес-вирус человека;
- вирус папилломы человека;
- бледная трепонема;
- мобилункус;
- бактероиды;
- гонококк;
- гарднерелла;
- микоплазма;
- уреаплазма;
- хламидии.
Мазок на инфекции в большинстве случаев является достаточно надежной диагностической процедурой. С его помощью можно выявить большинство серьезных заболеваний половой сферы, при этом стоимость анализа является вполне доступной даже в частных клиниках.
Кандидоз (та же молочница) может встретиться в любом возрасте у представителей любого пола.
Молочница является наиболее опасной для новорожденных детей и женщин в положении.
Именно по этой причине специалисты рекомендуют своим пациентам при любом признаке молочницы пройти обследование на данное заболевание.
В этой статье мы рассмотрим все виды анализов, которые сдают при подозрении на кандидоз.
Расскажем, как правильно подготовиться к анализу, и, какие типы анализов необходимо сдать для постановки точного диагноза.
Вы узнаете, какие признаки являются первыми предвестниками молочницы, и, куда обратиться, если Вы подозреваете у себя наличие этой инфекции.
Анализы на молочницу у женщин
Когда нужно сдать анализы на кандидоз.
Существуют определенные симптомы, при наличии которых, следует выполнить диагностические мероприятия.
Давайте разберем подробно эти признаки.
Предвестниками этой болезни могут быть такие факторы как:
- Боли и/или зуд в процессе мочеиспускания (чаще всего может появиться после полового акта). Эти очень неприятные ощущения могут усилиться перед сном или же при принятии теплой ванны.
- Выделения, цветом и структурой напоминающие творог.
Целесообразно обследование для женщин, у которых выявлены вульвовагинит, цервицит (воспаление шейки матки), уретрит или цистит.
Разберем, как проходит исследование при подозрении на молочницу.
В первую очередь, при наличии подозрительных симптомов, женщине следует обратиться на приём к врачу.
Он проведет осмотр половых органов и сделает предварительное заключение.
После осмотра, гинеколог или уролог может сделать забор мазков на анализ.
Осмотр и забор мазков проводит на гинекологическом кресле.
Это важно, так как в некоторых случаях, требуется взять мазки с шейки матки.
Кроме выполнения мазков, врач может порекомендовать и другие типы исследований которые помогут подтвердить диагноз молочницы.
Зачем сдавать анализы на молочницу?
В случае инфицирования грибковой инфекцией, не всё так просто.
Молочница или кандидоз может вызываться несколькими разновидностями грибка.
Среди них выделяют следующие виды:
- Candida albicans
- Candida tropicalis
- Candida globrata
Конечно, наиболее часто встречаются candida albicans.
Вторая причина в том, что часто грибок может быть резистентным к обычному лечению.
В этом случае, обязательно делают посев с определением чувствительности к препаратам.
Важно! Результат такого анализа поможет точно и безошибочно подобрать курс лечения.
Можно ли принимать антигрибковые препараты без обследования?
Очень часто люди злоупотребляют применением антимикотических препаратов, считая, что они безобидны.
Следует отметить, что все лекарства имеют свои побочные действия и не должны назначаться без достаточных показаний.
Грибковая инфекция часто может маскироваться.
При обследовании, часто выделяется смешанная флора.
Тогда требуется назначение комбинированного лечения.
Если человек будет принимать только антигрибковый препарат, бактериальная флора будет прогрессировать.
Такое лечение может затянуться и не принести положительного результата.
Если вам нужно лечение молочницы, обязательно обратитесь к специалисту.
Диагностика молочницы у мужчин
Разберем, какие признаки могут указывать на то, что у мужчины молочница.
Как ни странно, это заболевание диагностируется достаточно часто.
Возникновению процесса, способствует неправильный образ жизни, употребление спиртного сладкого и мучного.
Помните! Часто молочница возникает на фоне неконтролируемого приема антибактериальных препаратов
Первыми признаками у мужчин являются:
- Неприятный зуд
- Творожистые выделения
- Запах
- Болезненные ощущения при сексуальных контактах
Если мужчина заметил подобные проявления, следует немедленно обратиться к врачу для осмотра и назначения исследований.
стоит при клинических проявлениях и с такими заболеваниями, как:
- Баланопостит (воспаление головки и крайней плоти)
- Эпидидимит (воспаление яичек)
- простатит
- уретрит
- цистит
Своевременное обращение, обеспечит максимально быструю постановку диагноза.
Анализы на молочницу у ребенка
Родители часто спрашивают, может ли быть грибок у ребенка.
К сожалению, ответ положительный.
Дети часто заражаются кандидой, при несоблюдении гигиенических требований.
Обычно это происходит, через влажные мочалки или полотенца.
Источник инфекции в этом случае – один из родителей или член семьи.
Иммунная система у детей несовершенна, поэтому инфицируются они достаточно быстро.
Особенно опасен грибок для детей младшего возраста.
Важно! Способствует заражению грибковой флорой неправильное питание ребенка или лечение антибактериальными препаратами.
Если вам нужно сдать анализ ребёнку, следует подготовиться.
Выявить молочницу можно по результатам анализа крови, или путем забора мазка.
Какие анализы нужно сдать при молочнице
Всего существует несколько видов обследований на кандидоз.
Каждый из методов отличается от предыдущего не только названием, но и по принципу обнаружения кандиды.
Одними из самых популярных способов обнаружения молочницы на сегодняшний день является ПЦР .
Также, когда подозревается молочница, обследование может включать:
- микроскопию мазка из влагалища или уретры
- посев отделяемого уретры или влагалища
- ИФА анализ крови
Очень часто назначается одновременно несколько анализов, что очень значительно может повысить шансы на обнаружение этого заболевания.
Вагинальный мазок на молочницу
Если подозревается молочница, анализ мазка будет самым простым исследованием.
Мазок смотрят под микроскопом для того, чтобы выяснить, есть ли грибки в забранном биологическом материале.
Количество грибков при этом подсчитать не удастся.
Для этого используются другие (количественные) методы исследования.
Появление зуда и жжения в области половых органов, характерных белых выделений наводит пациенток на мысль о кандидозе. Возможно, молочницей болен и половой партнер. Чтобы точно определить, грибок ли это, женщине необходимо сделать анализ на молочницу. Если он подтвердится, аналогичное исследование делает и половой партнер.
Какие анализы сдавать на молочницу?
При подозрении на кандиду рекомендовано провести исследования, подтверждающие присутствие грибка в организме. В большинстве случаев (около 80%) врачи обнаруживают разновидность грибка кандида альбиканс – один из 150 грибков, поражающих наш организм.
В современности для этого часто используются:
- исследование мазка под микроскопом;
- бактериологический посев;
- иммуноферментный анализ;
- полимеразная цепная реакция.
Все способы диагностики имеют позитивные и негативные стороны, из-за чего врачи учитывают анализы при молочнице в комплексе, чтобы избежать диагностических ошибок.
Бактериальный посев – выделение исследуемого биологического материала и помещение его на питательную среду, в которой будут расти предполагаемые возбудители. Грибок кандида альбиканс активен в питательной среде – он активно размножается и выстраивает свои колонии, которые через время можно увидеть даже без микроскопа. Выращивание грибков на питательной среде достаточно популярно, поскольку при данном исследовании врач определяет чувствительность грибков к лекарственным препаратам.
ИФА анализ на кандидоз. Иммуноферментное исследование на антитела является не менее точным, чем полимеразная цепная реакция. При попадании возбудителя в организм начинается выработка специфических антител против грибка. Доказав наличие антител к кандиде альбиканс, можно автоматически констатировать присутствие грибка в организме.
К ним относится мазок на выделение грибка. В частности, при проведении такого анализа медики обращают внимание на параметры:
- увеличенное количество лейкоцитов, что возможно при кандидозе;
- присутствие в мазке атипичных клеток, которые присутствуют в мазке при наличии грибкового поражения организма;
- непосредственное обнаружение в мазке грибка кандида.
Поскольку у женщин молочница встречается чаще и симптомы ее выражены ярче, чем у мужчин, врачи уже заранее могут заподозрить кандидоз. Для уточнения диагноза медики чаще всего назначают бактериологический посев выделений из влагалища.
Это наиболее благодатная среда для исследования, поскольку при наличии грибка он будет именно во влагалищной микрофлоре достигать показательного уровня, хотя поражает молочница и область рта, кишечника. Мазок берется во время обычного гинекологического осмотра, желательно не перед менструациями.
Для представителей сильного пола основным методом определения кандида альбиканс является взятие мазка и микроскопическое исследование материала. Обычно этого хватает, чтобы сделать анализ на молочницу у мужчин и подтвердить, или опровергнуть результат.
Если есть симптомы того, что кандидоз поразил не только половые органы, но и мочевой пузырь, то для подтверждения надо сдать анализ мочи.
Мазок берется с поверхности головки полового члена и из уретры. Если анализ мочи показывает молочницу, значит, инфекция поразила и уретру, возможно – и мочевой пузырь. Подобного рода исследования проводятся практически безболезненно.
Куда нужно обращаться?
Молочница является наиболее распространенной инфекцией половых органов. Поэтому анализы на определение заболевания проводятся давно, и определить кандидоз не составляет труда. При подозрении на молочницу пациенты в большинстве своем обращаются в обычную больницу. К слову, можно сделать исследование и в частной клинике.
По наблюдениям пациентов, лучше всего сдавать биоматериал там, где работает лечащий врач – связь с лабораторией быстрая, нет необходимости ездить в разные места за результатами, а в частных клиниках и вовсе результат при повторном посещении будет уже в кабинете у доктора.
Сколько стоит?
При выборе лаборатории можно воспользоваться акционными предложениями. Многие лаборатории делают скидки на определенные виды анализов, стоимость будет существенно меньше, а вот результат от этого не изменится. Единственное неудобство в работе таких лабораторий – результат необходимо забирать и отвозить доктору самостоятельно. Некоторые диагностические центры отправляют результаты на электронную почту (услуга входит в стоимость).
При выборе лаборатории стоит учесть, что в городах-мегаполисах России цена исследования будет отличаться на пару сотен рублей от цены в другом, менее крупном городе. Иммуноферментный анализ на кандиду в Москве стоит приблизительно 700-800 рублей, а вот мазок вдвое дешевле – 350-400 рублей.
Как часто сдавать анализ на кандидоз?
Анализ на кандидоз сдают не часто – достаточно один раз определить наличие грибка, после чего женщине и мужчине назначают лечение, и повторный анализ уже сдается после терапии. Стандартный курс лечения молочницы составляет от 5 до семи 7 дней, но в некоторых случаях терапия затягивается до десяти суток.
Если вторично получены хорошие анализы, другие исследования не проводятся. При желании пациент или пациентка могу по собственной инициативе сдать анализ, при проявлении первичных симптомов кандидоза.
Выявить молочницу в организме несложно – при поражении гениталий анализы показывают высокие цифры присутствия кандиды альбиканс в организме. Двусмысленных толкований быть не может – диагноз подтверждается, и врач назначает необходимое лечение.
Инфекции, передаваемые половым путем, грозят всем, кто занимается сексом. Но женщинам повезло меньше, чем мужчинам: вероятность заразиться ИППП у них выше, а обнаружить болезнь сложнее. Единственный способ защитить здоровье — сдавать анализы каждый раз после секса без презерватива с непроверенным партнером. А иногда — и с проверенным.
Оглавление на экстренный случай
Почему женщины рискуют больше?
Из-за особенностей анатомии. Слизистая влагалища и вульвы тоньше, чем кожа полового члена. Поэтому она чаще травмируется, и микробам легче преодолеть защитный барьер. К тому же, во влагалище тепло и влажно, это комфортная среда для возбудителей инфекций.
Из-за отсутствия симптомов. Хламидиоз и гонорея у женщин чаще, чем у мужчин, протекают бессимптомно. А внешние проявления сифилиса, герпеса или папилломавирусной инфекции иногда невозможно заметить: женщина не каждый день осматривает вульву, тогда как мужчина видит свой половой член несколько раз в день.
Несколько лет назад гинеколог диагностировала у Маши молочницу: девушка жаловалась на зуд и выделения, а в мазке выявили грибки в высокой концентрации. Доктор выписала Маше противогрибковые свечи, и через неделю лечения все симптомы исчезли.
Спустя год Маша снова заметила выделения и почувствовала зуд во влагалище. Незадолго до этого у девушки был случайный секс, но она решила, что это снова молочница, нашла старый рецепт и купила свечи. Через неделю симптомы исчезли, и Маша забыла об этом случае.
Чем женщина может заразиться во время секса?
В России распространены десять инфекций [1]. Одни передаются исключительно во время секса, а некоторые еще и через кровь.
Чем опасна. Вызывает воспаление матки, яичников, маточных труб, брюшной полости, появление спаек, бесплодие, поражения полости рта, глаз, костей, суставов и других органов. При беременности — инфицирование плода, преждевременные роды.
Вылечить инфекцию бывает трудно из-за ее устойчивости к антибиотикам.
Чем опасна. Вызывает воспаление матки, яичников, маточных труб, брюшной полости, появление спаек, бесплодие, при беременности — инфицирование плода, преждевременные роды.
выявленных ИППП в России — трихомониаз
Чем опасна. Вызывает воспаление матки, яичников, маточных труб, брюшной полости, появление спаек, бесплодие, поражение глаз, суставов. При беременности — инфицирование плода, преждевременные роды.
Herpes simplex virus (HSV-1,2)
Чем опасна. Вызывает повторяющиеся болезненные высыпания на половых губах , коже промежности и во влагалище, уретре. При беременности — инфицирование плода, преждевременные роды, вирус остается в организме всю жизнь и передается половым партнерам.
Чем опасна. Вызывает воспаление матки, яичников, маточных труб, брюшной полости, появление спаек, бесплодие, при беременности — инфицирование плода, преждевременные роды.
Чем опасна. Вызывает воспаление матки, яичников, маточных труб, брюшной полости, появление спаек, бесплодие, поражения сердца, аорты, спинного и головного мозга и других органов. При беременности — инфицирование плода, преждевременные роды.
Human Papillomavirus (HPV — 16,18)
Чем опасна. Вызывает рак шейки матки, полости рта и ануса.
Human immunodeficiency virus — HIV
Чем опасна. Вызывает прогрессирование до СПИД, присоединение инфекций, злокачественные опухоли, при беременности — инфицирование плода.
Hepatitis B virus, HBV
Чем опасна. Вызывает рак цирроз, рак печени, при беременности — инфицирование плода.
Hepatitis C virus, HCV
Чем опасна. Вызывает рак цирроз, рак печени, при беременности — инфицирование плода.
ИППП — одна из распространенных причин женского бесплодия. Инфекции провоцируют хроническое воспаление органов малого таза. А воспаление иногда приводит к непроходимости маточных труб: яйцеклетки не попадают в матку из яичников, что мешает зачатию или нормальному развитию беременности. Чтобы решить проблему, приходится прибегать к репродуктивным технологиям — таким, как ЭКО.
Безграмотные врачи говорят, что чем больше у женщины было сексуальных партнеров — тем выше риск бесплодия. Но это не так. Рискуют те, кто практикуют незащищенный секс и не проверяются на ИППП.
Знакомься
2. Заполни анкету
3. Получи бесплатный анализ своего питания от персонального наставника
Как часто нужно проверяться, если ничего не беспокоит?
Согласно рекомендациям Американского онкологического общества, женщинам 30-65 лет каждые 5 лет нужно сдавать мазок из влагалища для определения вируса папилломы человека 16 и 18 типов методом ПЦР. Узнайте у своего гинеколога, нужно ли вам пройти это исследование в ближайшее время.
полимеразная цепная реакция
Всем без исключения женщинам стоит сдать тест на ВИЧ хотя бы раз за период с 15 до 65 лет.
Регулярно сдавать анализы на все ИППП нужно женщинам любого возраста из группы риска [2]. В нее входят те, кто:
уже болели ИППП в прошлом,
занимаются сексом без презерватива с новыми партнерами,
состоят в открытых отношениях: когда постоянный партнер занимается сексом с другими женщинами или мужчинами,
занимаются групповым сексом,
имеют ВИЧ-положительный статус,
употребляют наркотики внутривенно или через нос,
работает в сфере секс-услуг.
Нужно ли специально просить гинеколога взять анализы на ИППП?
Скорее нет, чем да. Мазок из влагалища — рутинный анализ в гинекологии. Вооружив глаз микроскопом, лаборант может увидеть и посчитать в образце лейкоциты, бактерий, которые в норме обитают в женских половых путях, грибки и некоторые патогенные микроорганизмы — например, возбудителей гонореи и трихомониаза. Но если вредных микробов в анализе не обнаружится — это еще не означает, что инфекции нет. Поэтому нужно перепроверить результат с помощью ПЦР-исследования.
Кстати, помимо ПЦР для диагностики ИППП существует метод высокой чувствительности – NASBA (НАСБА, определение РНК). Он определяет очень низкие концентрации возбудителей ИППП, что часто встречается при стертых формах течения болезни или в инкубационный период. Исследование НАСБА часто назначают при сомнительных результатах методом ПЦР.
Что делать, если.
Пить без назначения врача антибактериальные, противопаразитарные и противовирусные препараты или использовать их в виде свечей. Можно ошибиться с выбором лекарства и его дозой. Это повлияет на результаты анализов, в итоге правильное лечение доктор назначит с опозданием.
Бежать в лабораторию сразу после незащищенного секса. Даже современные и точные ПЦР-тесты обнаруживают инфекцию только после инкубационного периода. Для этого требуется несколько дней — торопиться нет смысла.
Чтобы исключить все ИППП, придется сдать анализы три раза:
Через неделю после подозрительного полового контакта — мазок из влагалища, чтобы выявить возбудителей гонореи, хламидиоза, трихомониаза, микоплазмы гениталиум, вирусов простого герпеса, вируса папилломы человека 16 и 18 типов при помощи ПЦР или НАСБА.
Через 1—1,5 месяца сдать кровь из вены на сифилис и гепатиты.
Через 3 месяца — кровь на ВИЧ и повторно на сифилис и гепатиты.
Если врач, к которому вы обратились, чтобы провериться на ИППП, сразу не назначил вам анализы на ВПЧ и герпес — это нормально. Вероятно, он возьмет дополнительные мазки после того, как исключит бактериальные инфекции.
Можно ли провериться на ИППП во время месячных?
«Не стоит сдавать мазки на ПЦР-диагностику половых инфекций в дни менструации. Также нежелательно делать это
- сразу после вагинальных исследований: УЗИ, кольпоскопия;
- после использования накануне вагинальных свечей или спринцеваний;
- когда пьете антибиотики.
Выделения, зуд и неприятный запах не всегда означают ИППП. Помимо венерических заболеваний, у этих симптомов могут быть и другие причины.
Цистит. Если вас беспокоит зуд, жжение при мочеиспускании и вы стали часто ходить в туалет, но при этом нет выделений и запаха — возможно, это воспаление мочевого пузыря. С такими жалобами будет правильно обратиться к урологу.
Агрессивный секс. Чрезмерная активность иногда приводит к повреждению слизистой вульвы.
В любом случае, если вас беспокоят необычные выделения из влагалища, зуд, жжение или появилась сыпь на половых органах — запишитесь на прием к врачу. Подойдет дерматовенеролог или гинеколог — и тот, и другой умеют диагностировать и лечить ИППП.
ИППП могут приводить к инфицированию плода [1], преждевременные родам и послеродовым осложнениям. Поэтому на этапе планирования беременности стоит провериться на инфекции, сдав мазок из влагалища для определения возбудителей гонореи, хламидиоза, трихомониаза, микоплазмы гениталиум, вирусов простого герпеса методом ПЦР или НАСБА и кровь на сифилис, ВИЧ и гепатиты В и С.
В России у каждой беременной женщины, которая встает на учет в женскую консультацию, берут:
анализ крови на ВИЧ, сифилис и гепатиты В и С,
анализ крови на выявление герпеса методом ИФА (в составе анализа на ToRCH-инфекции).
Этот набор исследований утвержден Минздравом. Он почти полностью соответствует зарубежным рекомендациям по скринингу во время беременности. Только на Западе женщинам до 25 лет советуют выявлять гонорею и хламидиоз в мазке методом ПЦР вместо нашего мазка на флору. И считают нецелесообразным обследоваться на герпес.
Как выглядит справка об отсутствии половых инфекций у здорового мужчины, мы уже показывали. Перешлите ему статью.
А вот справка здоровой женщины:
Да. Во-первых, заразиться можно при анальном и оральном половом контакте. Во-вторых, венерические инфекции передаются и менее очевидными путями.
Занимаясь петтингом, целуясь или лаская партнера пальцами, можно заразиться любой ИППП [4], но легче всего — генитальным герпесом, вирусом папилломы человека и сифилисом.
У стоматолога, в маникюрном или тату-салоне, потенциально можно заразиться гепатитами В и С от инструментов, хоть риск и невелик [5].
Употребляя наркотики через нос можно заразиться гепатитом С. Исследования показали, что частицы вируса проникают в носовую слизь с коктейльных соломинок, которые компании по очереди используют на вечеринках, чтобы втянуть порцию кокаина или героина [6,7].
Напротив, микробы, вызывающие ИППП, плохо выживают во внешней среде. Поэтому ими нельзя заразиться:
от туалетных сидений,
при посещении бассейна,
при приеме ванны,
от дверных ручек,
при использовании общей одежды, полотенец или посуды.
Как не заразиться ИППП через секс-игрушки?
Проверяться все равно нужно. Вы можете заразиться ИППП:
при прикосновениях к гениталиям;
при контакте кожи с кожей, со слизистой оболочкой рта и половых органов.
Специальных рекомендаций по обследованию международные экспертные сообщества не дают, поэтому стоит проверяться по стандартной схеме после каждого полового акта с новой партнершей. И избегать секса во время месячных — при попадании крови на слизистые оболочки заразиться гораздо легче.
Как защититься от ИППП при сексе между женщинами?
«Вариантов защиты от ИППП у ЖСЖ (женщин, практикующих секс с женщинами) не так много. Для мануальных ласк — это, как правило, латексные перчатки. Хирургические — самые тонкие и прочные. Для орального секса — специальные латексные салфетки. Во время кунилингуса или анилингуса салфетка прикладывается, соответственно, к вульве или к анусу, и, собственно, через нее осуществляются ласки. Это снижает риск попадания микрофлоры со слизистых в полость рта и наоборот. Не сказать, что такие салфетки продаются на каждом углу, поэтому женщины частенько прибегают к хендмейд-вариантам. Выкраивают салфетку либо из презерватива, либо из обычной пищевой пленки. При этом надо иметь в виду, что использование салфеток не гарантирует, что вы ничем не заразитесь.
Где сдать анализы на ИППП?
Государственный кожно-венерологический диспансер. Возможно вам будет неуютно внутри и придется постоять в очереди, зато часть анализов можно сдать бесплатно по ОМС. Но по закону врач сам определяет, какие обследования нужны, а какие — нет. Это значит, что у него может не оказаться бесплатных направлений на ПЦР-диагностику, и он предложит вам только мазок на флору. Сопоставьте направление на анализы, которое получите после консультации, с нашим списком и если чего-то не хватает —пройдите недостающие исследования в частной лаборатории за свой счет.
Частная клиника. Попасть на прием гораздо проще — можно записаться в ближайшую к дому или офису клинику на любое удобное время, не нужно ждать в очередях, внутри чисто и комфортно. Но будьте внимательны: в частном медицинском центре вам могут назначить неинформативные анализы.
Перечисленные методы диагностики не входят в отечественные и зарубежные клинические рекомендации по первичной диагностике ИППП [2,8]. Если врач назначил вам несколько десятков анализов и не может доступно объяснить зачем — запишитесь на прием к другому врачу.
Частная лаборатория. В любой частной лаборатории есть выгодные предложения по комплексному обследованию на ИППП. Внимательно изучите, что в них входит — иногда там встречаются неинформативные анализы: ПЦР на вирусы папилломы с низким онкогенным риском 6 и 11 типа, цитомегаловирус, условно-патогенные микроорганизмы (Mycoplasma hominis, Ureaplasma parvum и Ureaplasma urealyticum). Наличие этих микробов в организме не скажется на вашем здоровье.
Список от известного гинеколога Татьяны Румянцевой, которая помогала нам писать эту статью, — вам в помощь.
Читайте также: